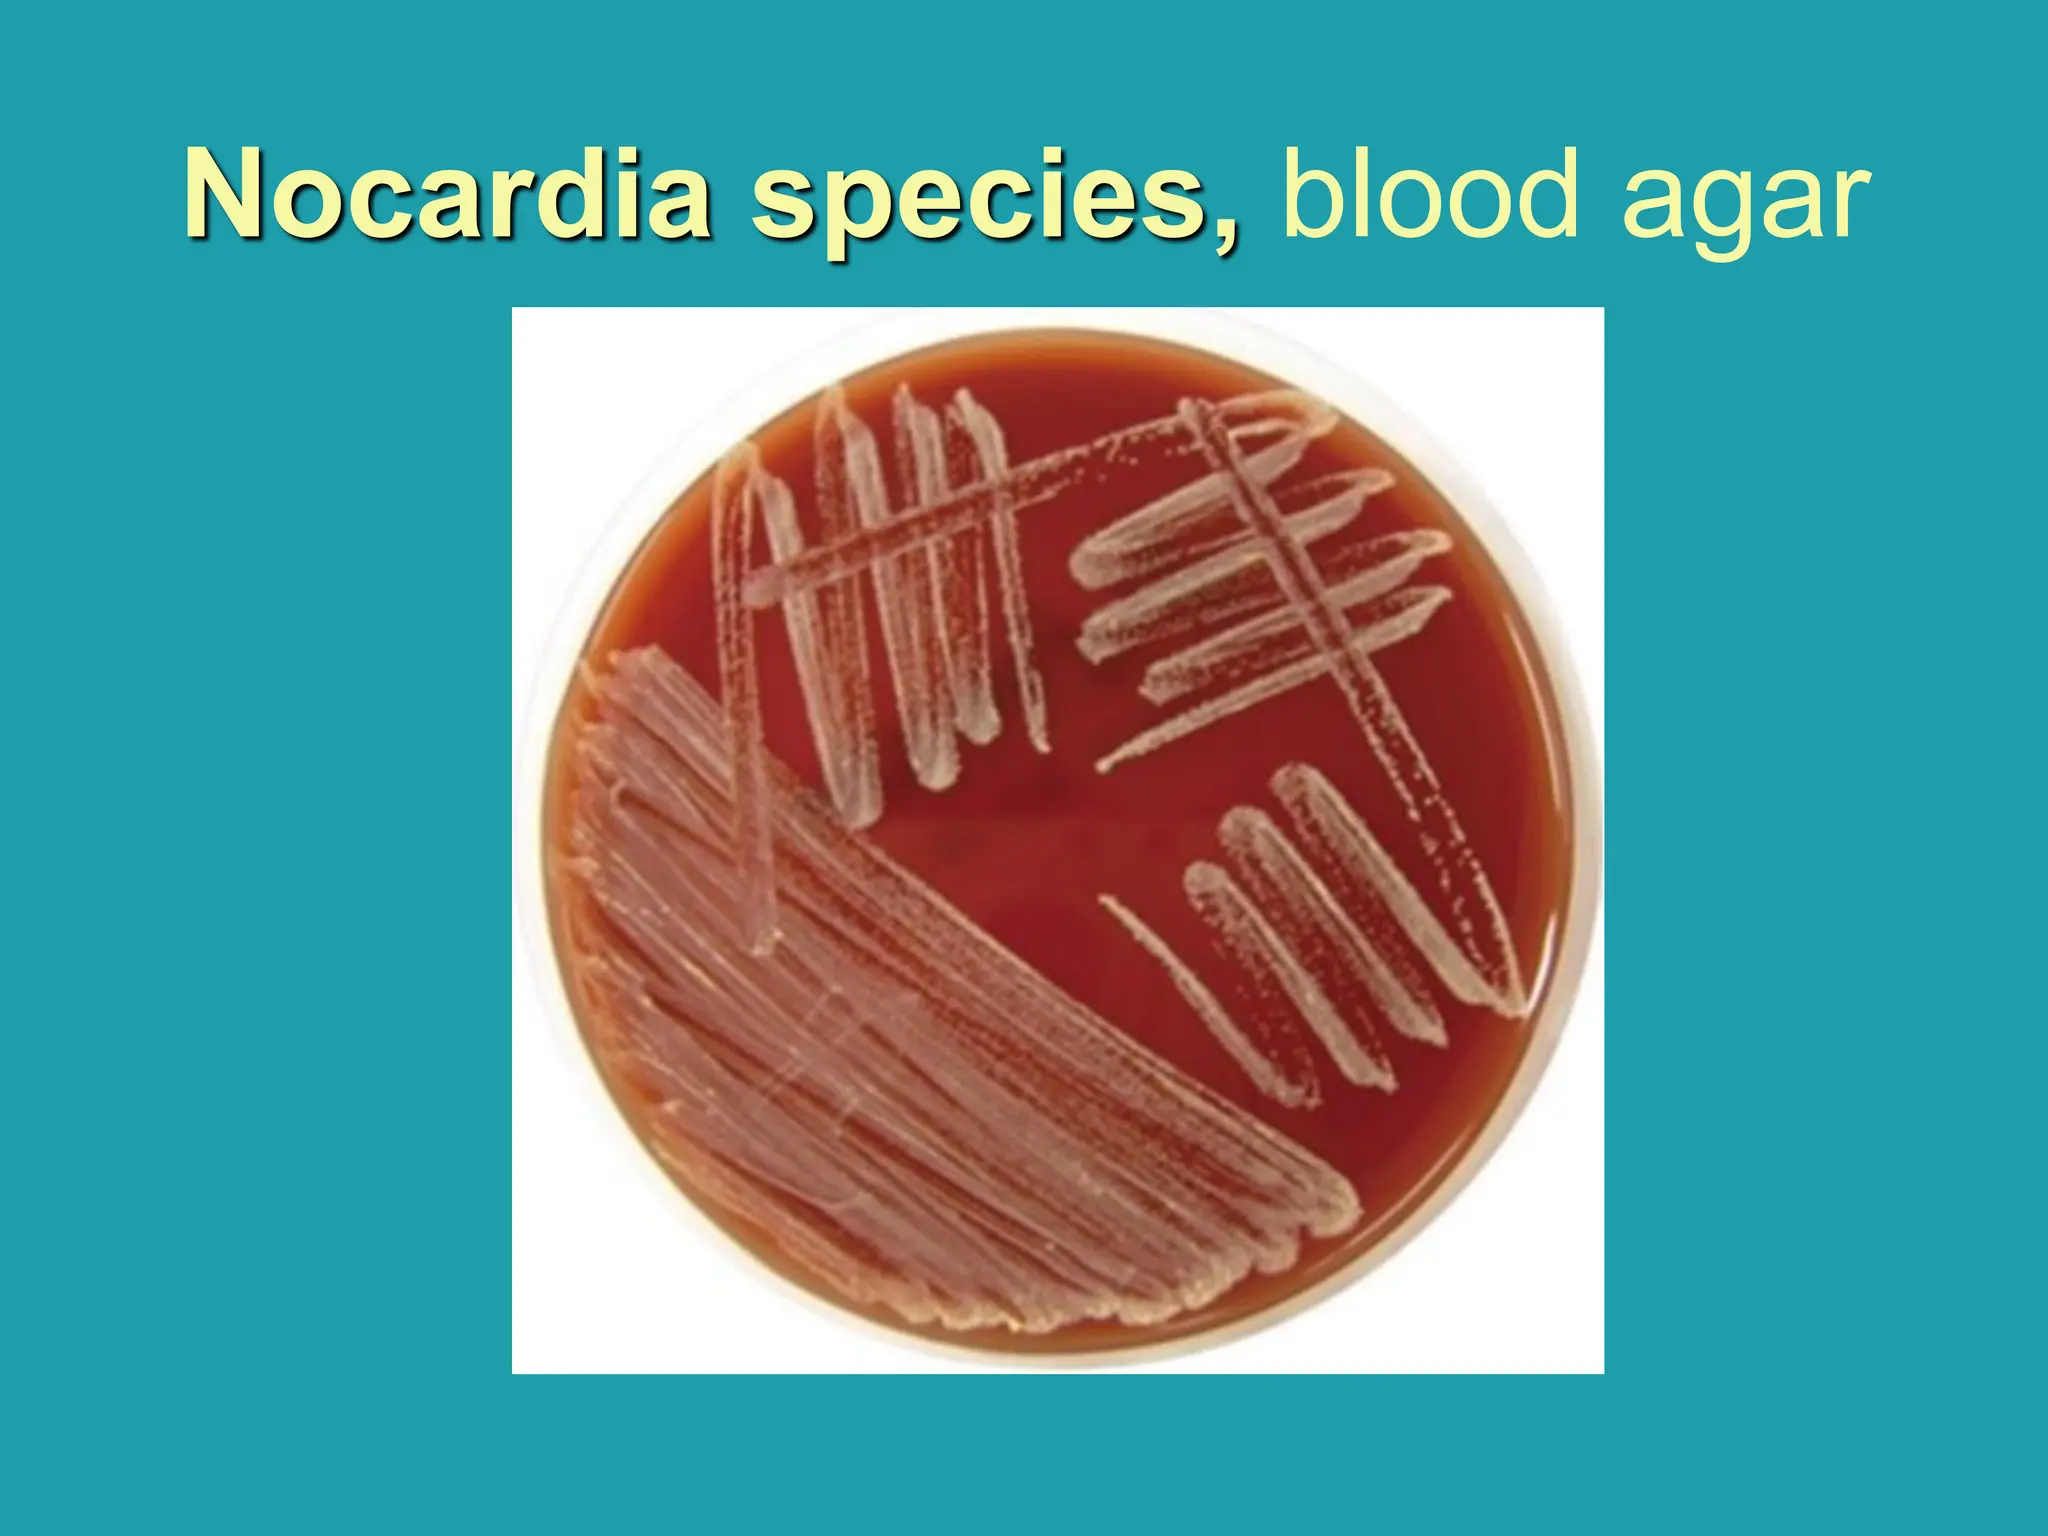
Nocardia species, blood agar
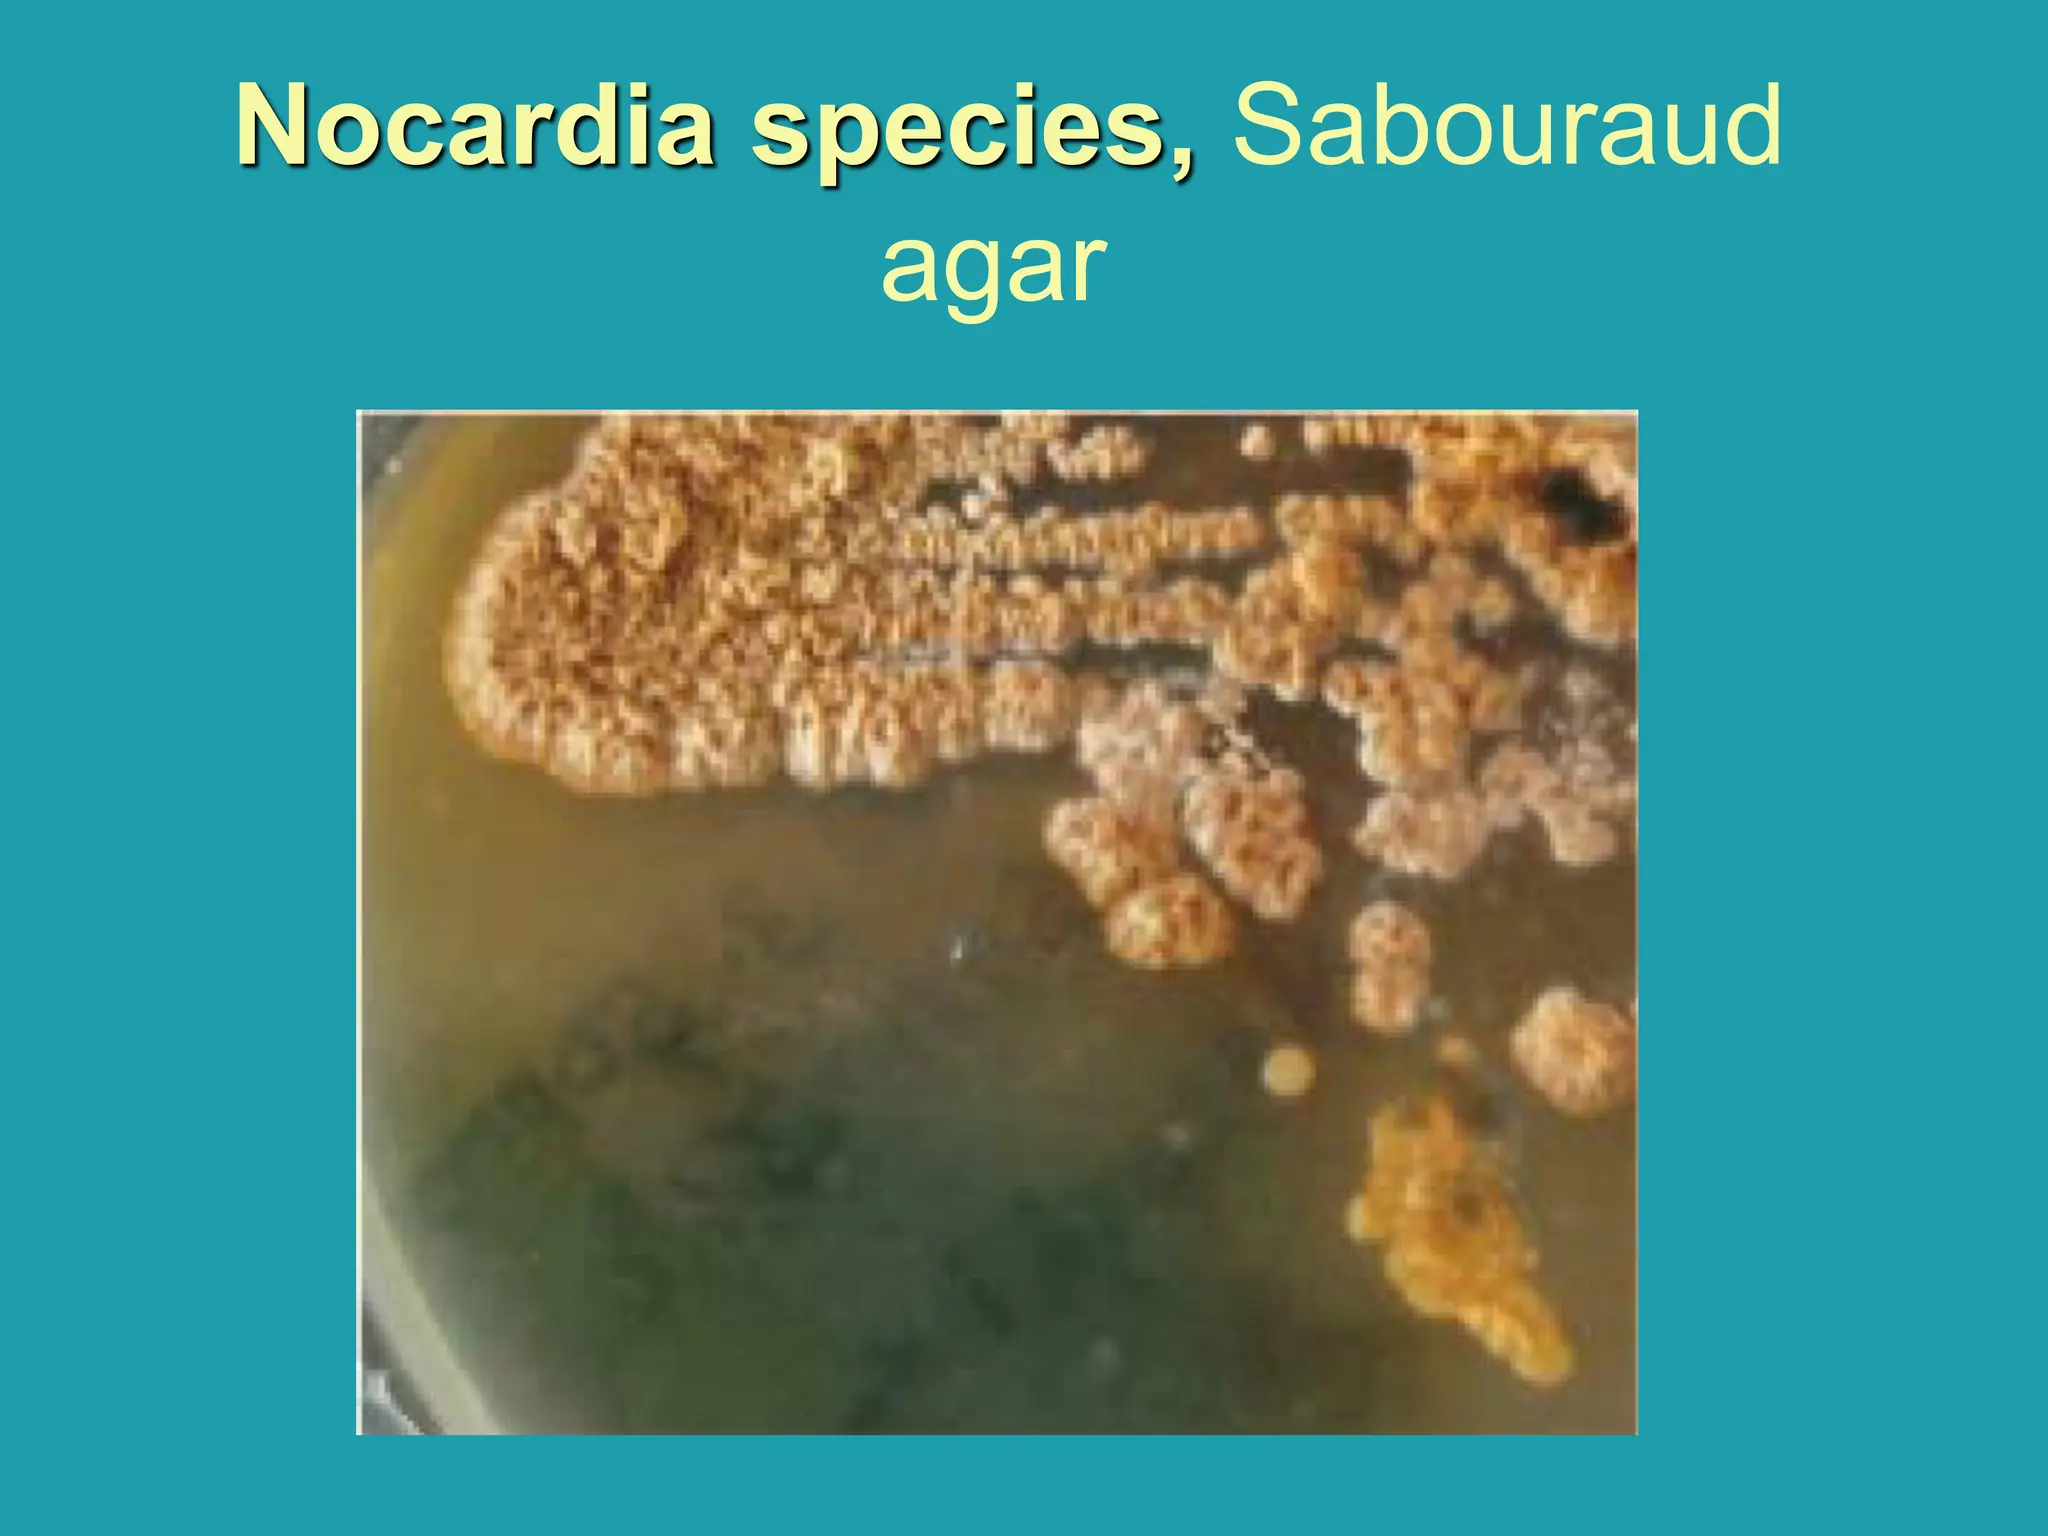
Nocardia species, Sabouraud
agar
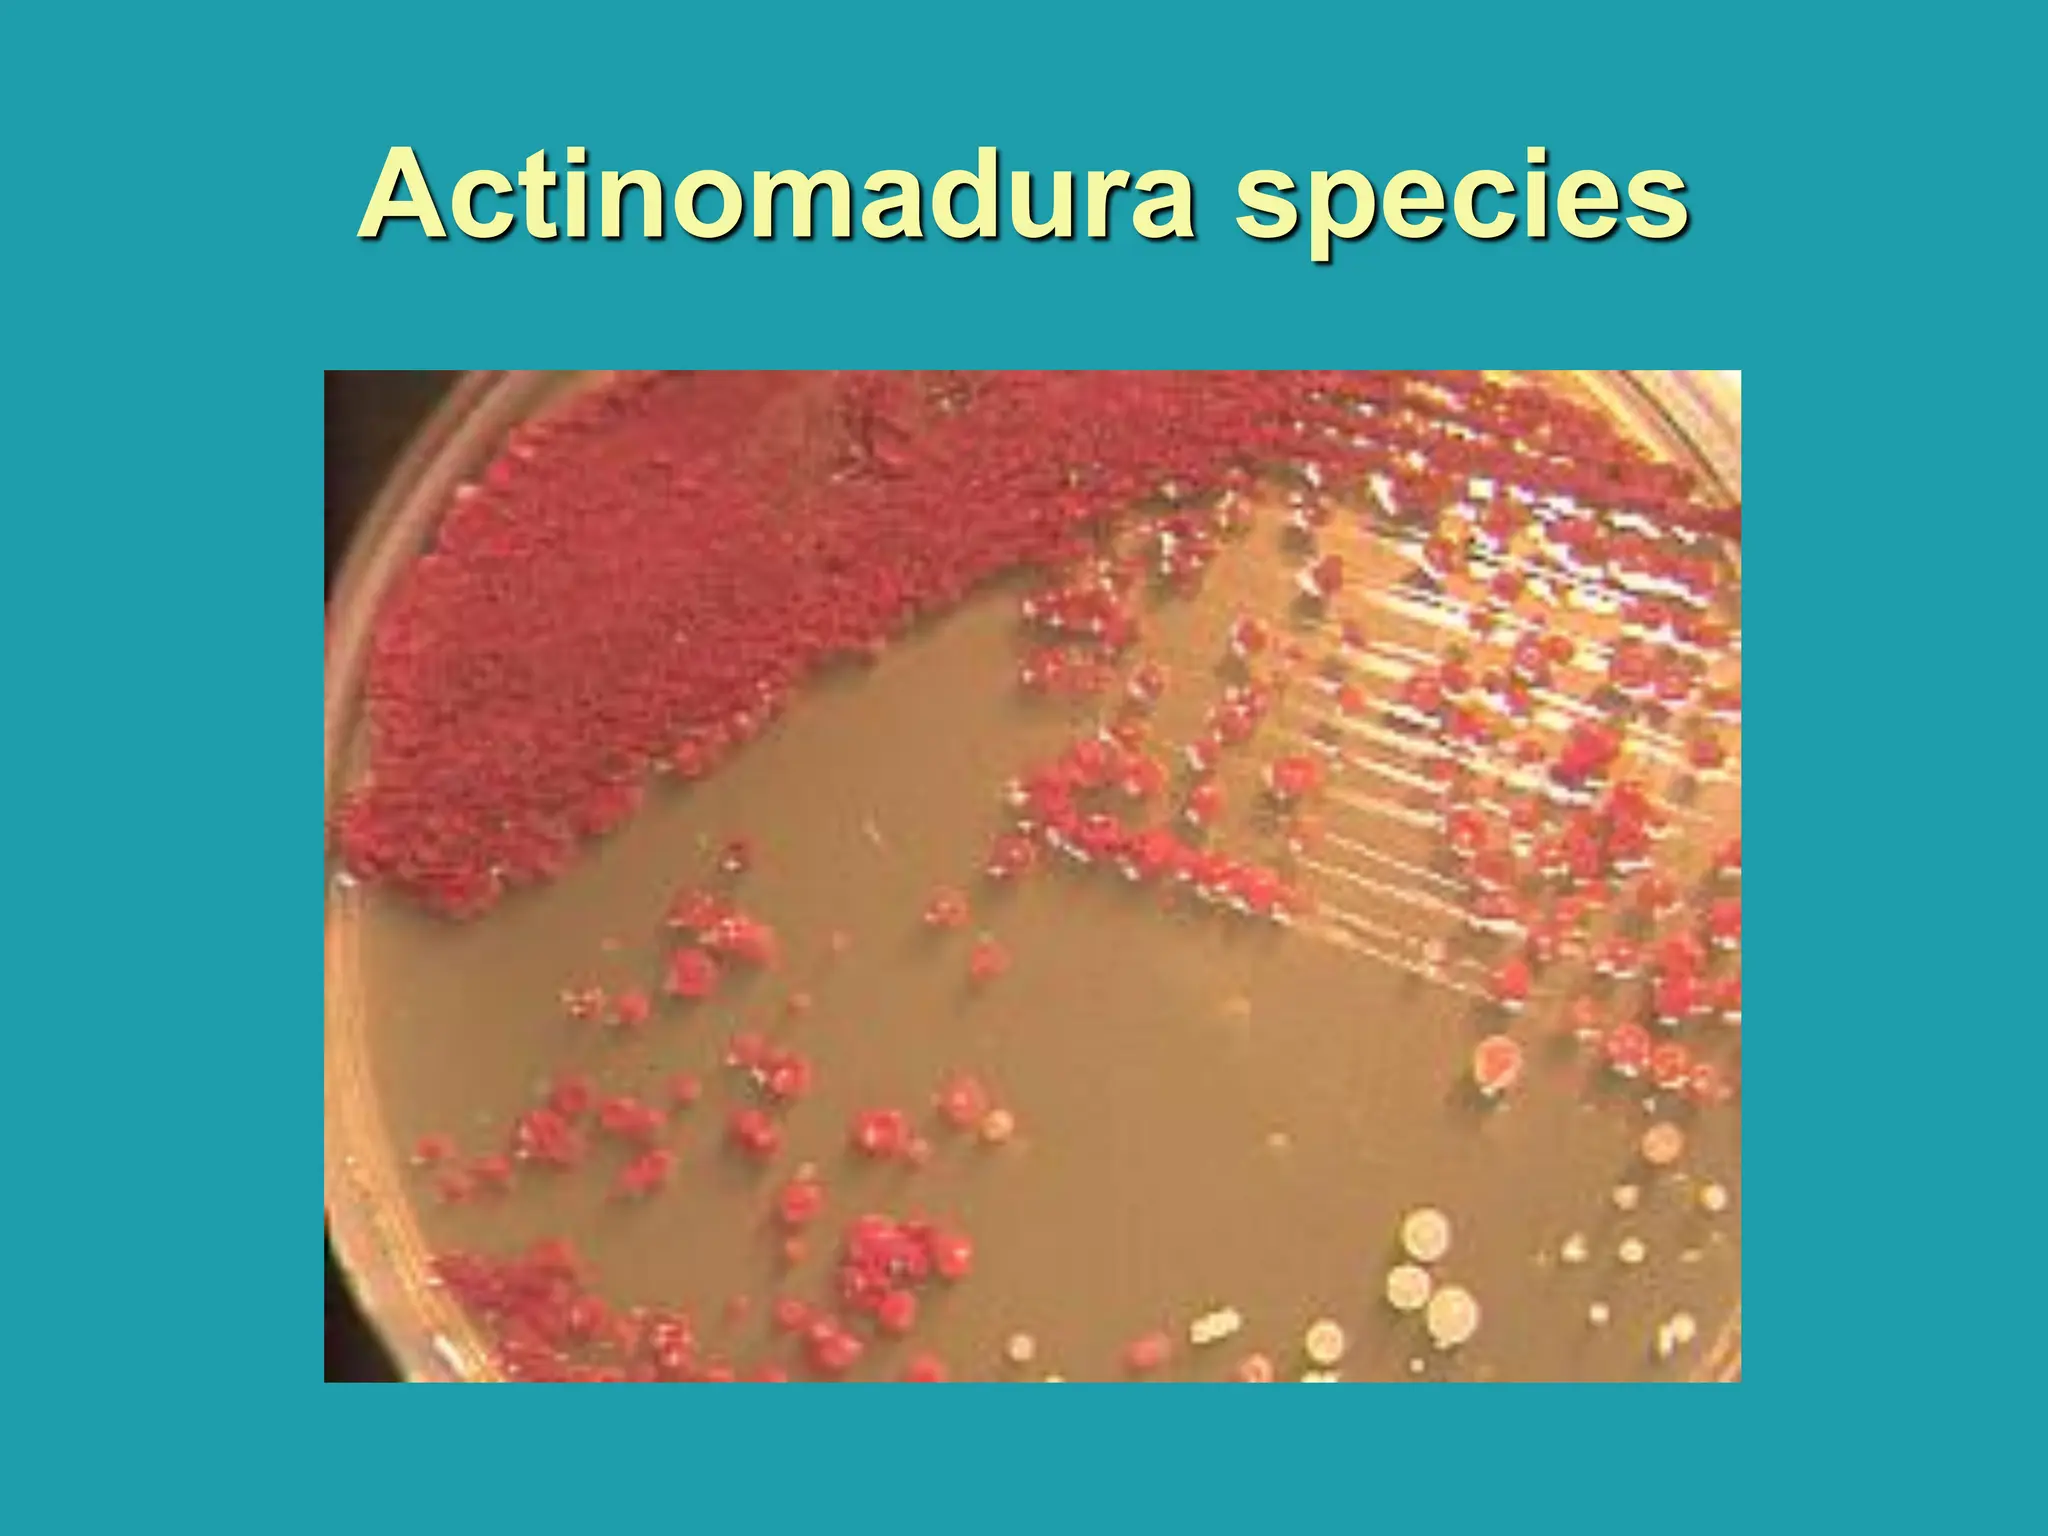
Actinomadura species
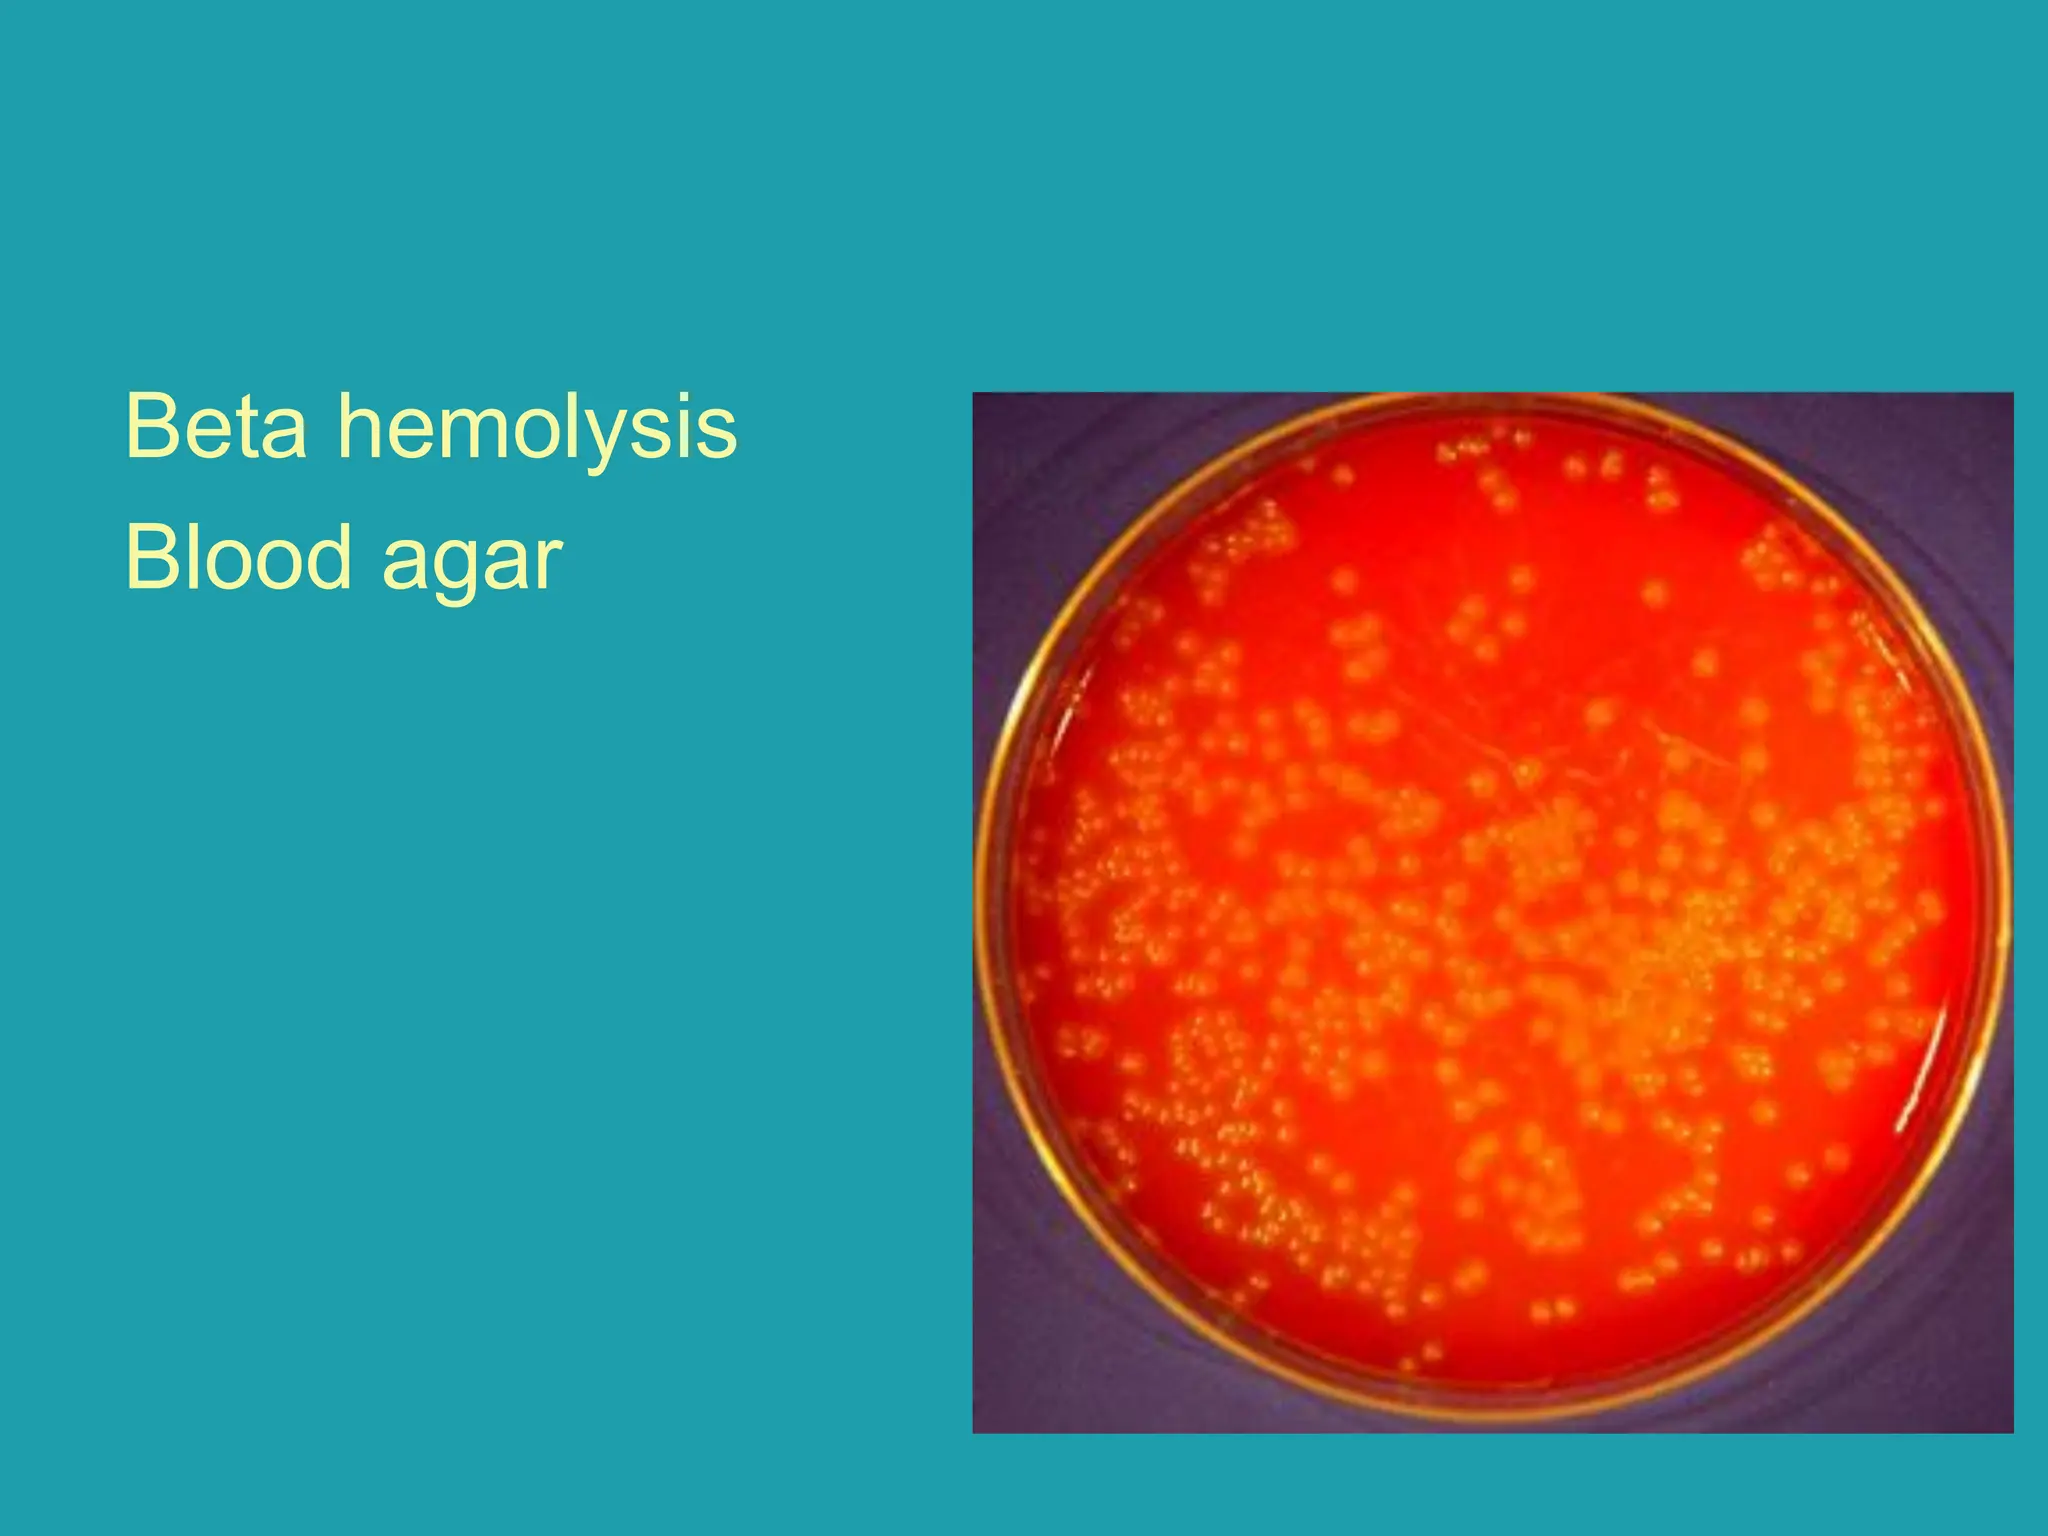
Beta hemolysis
Blood agar
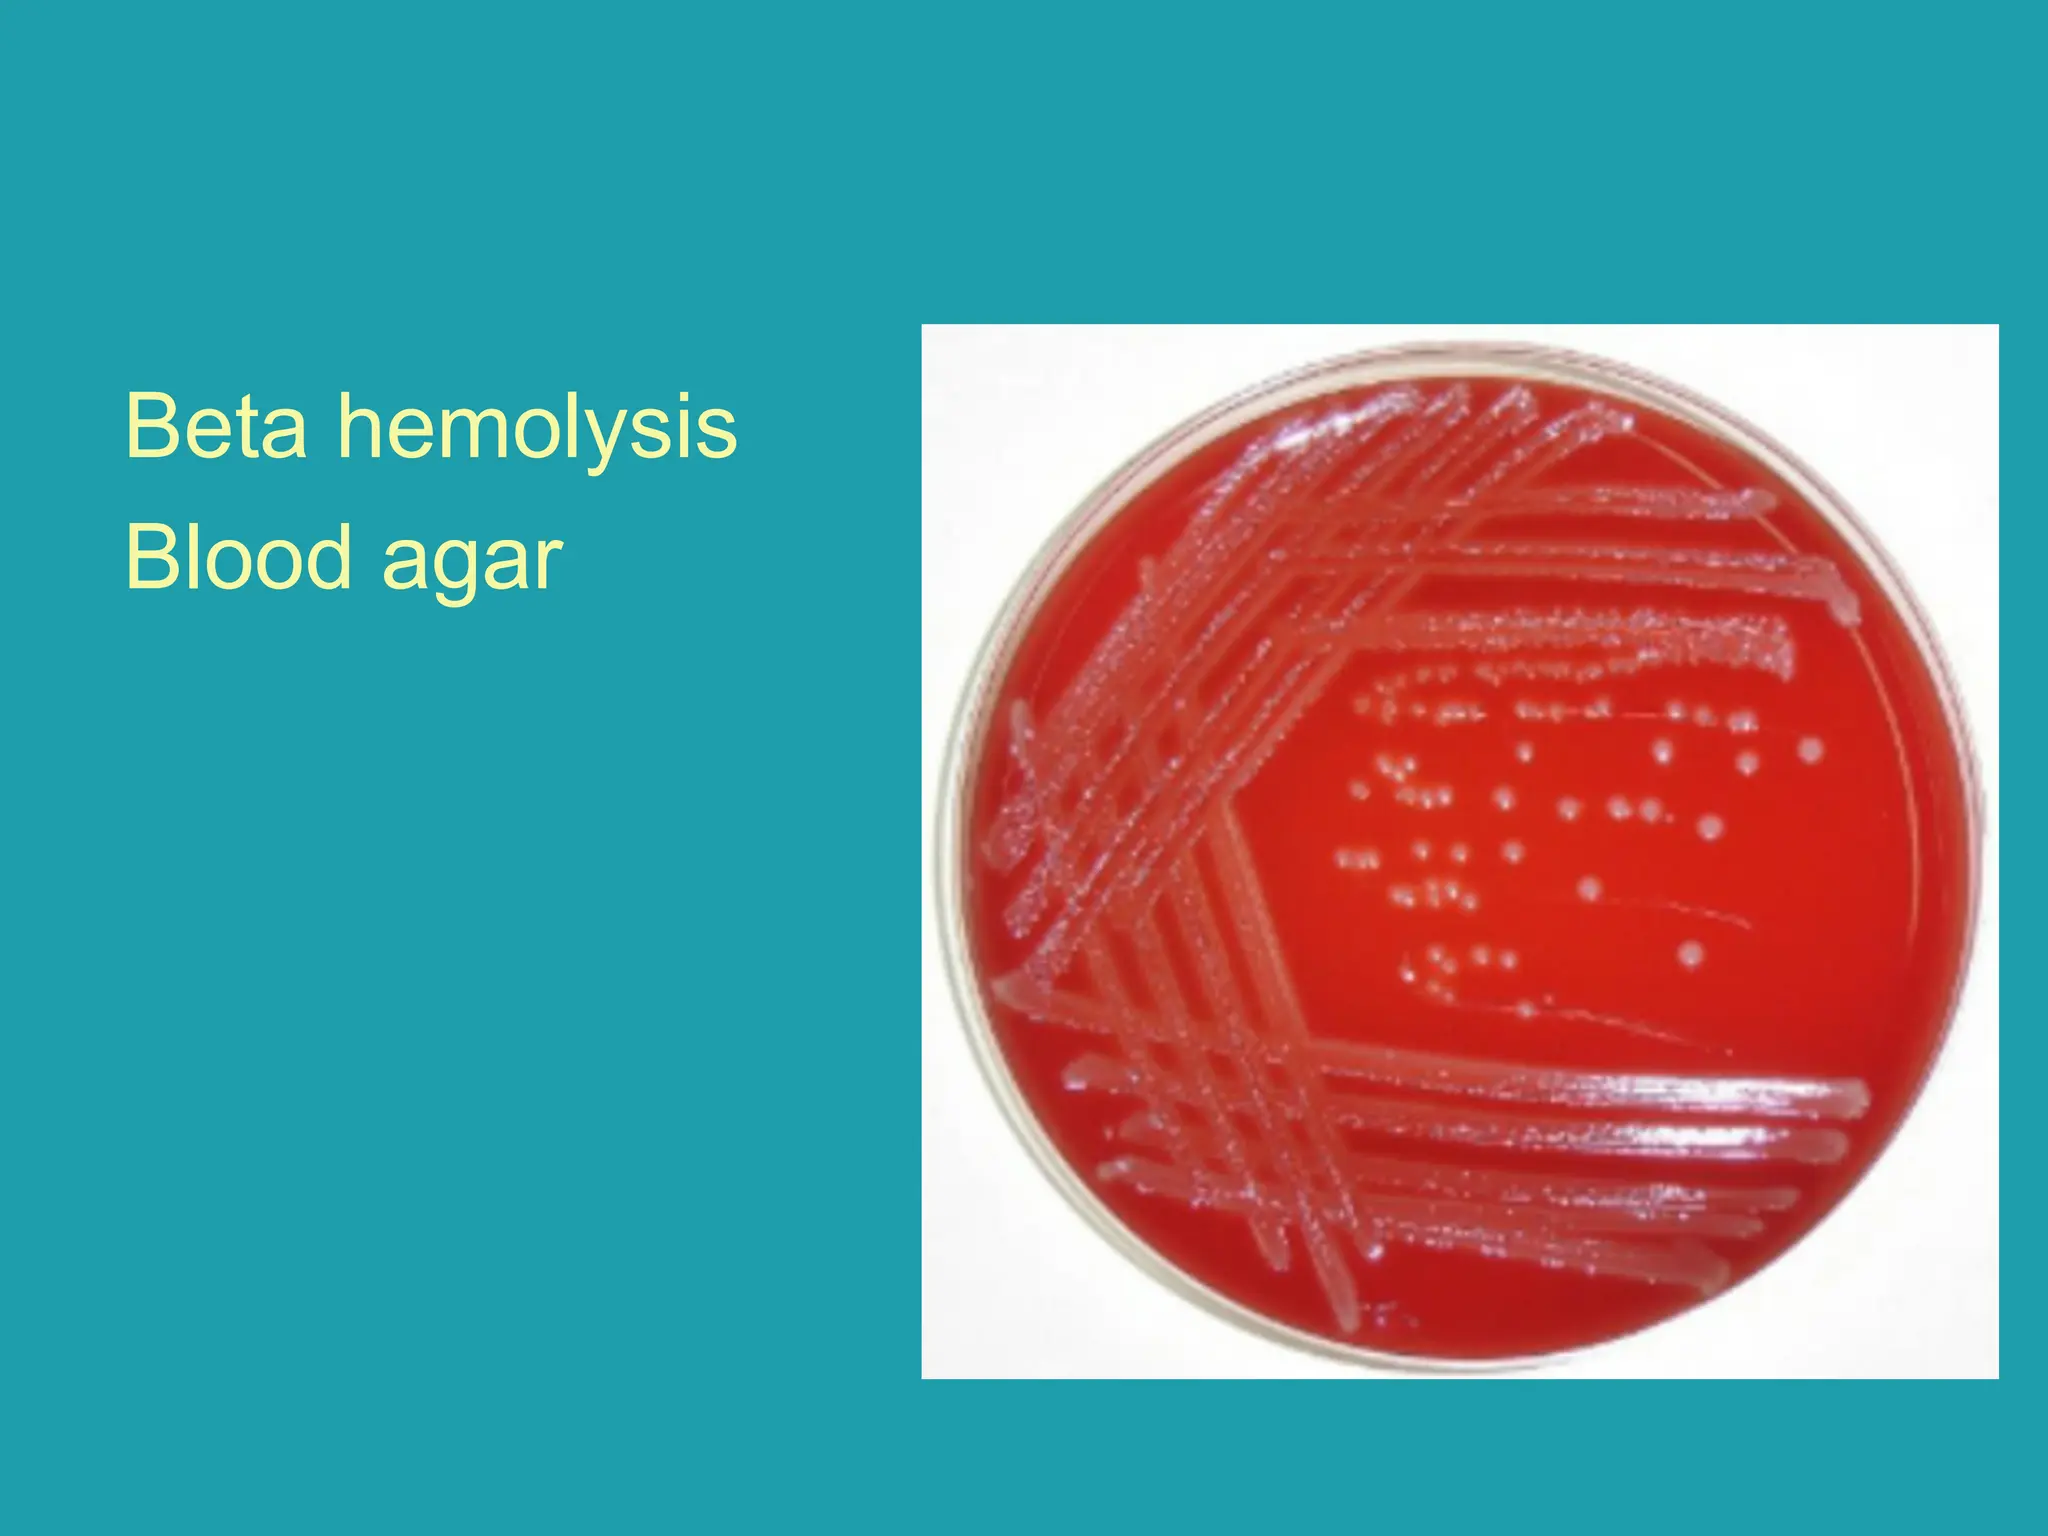
Beta hemolysis
Blood agar
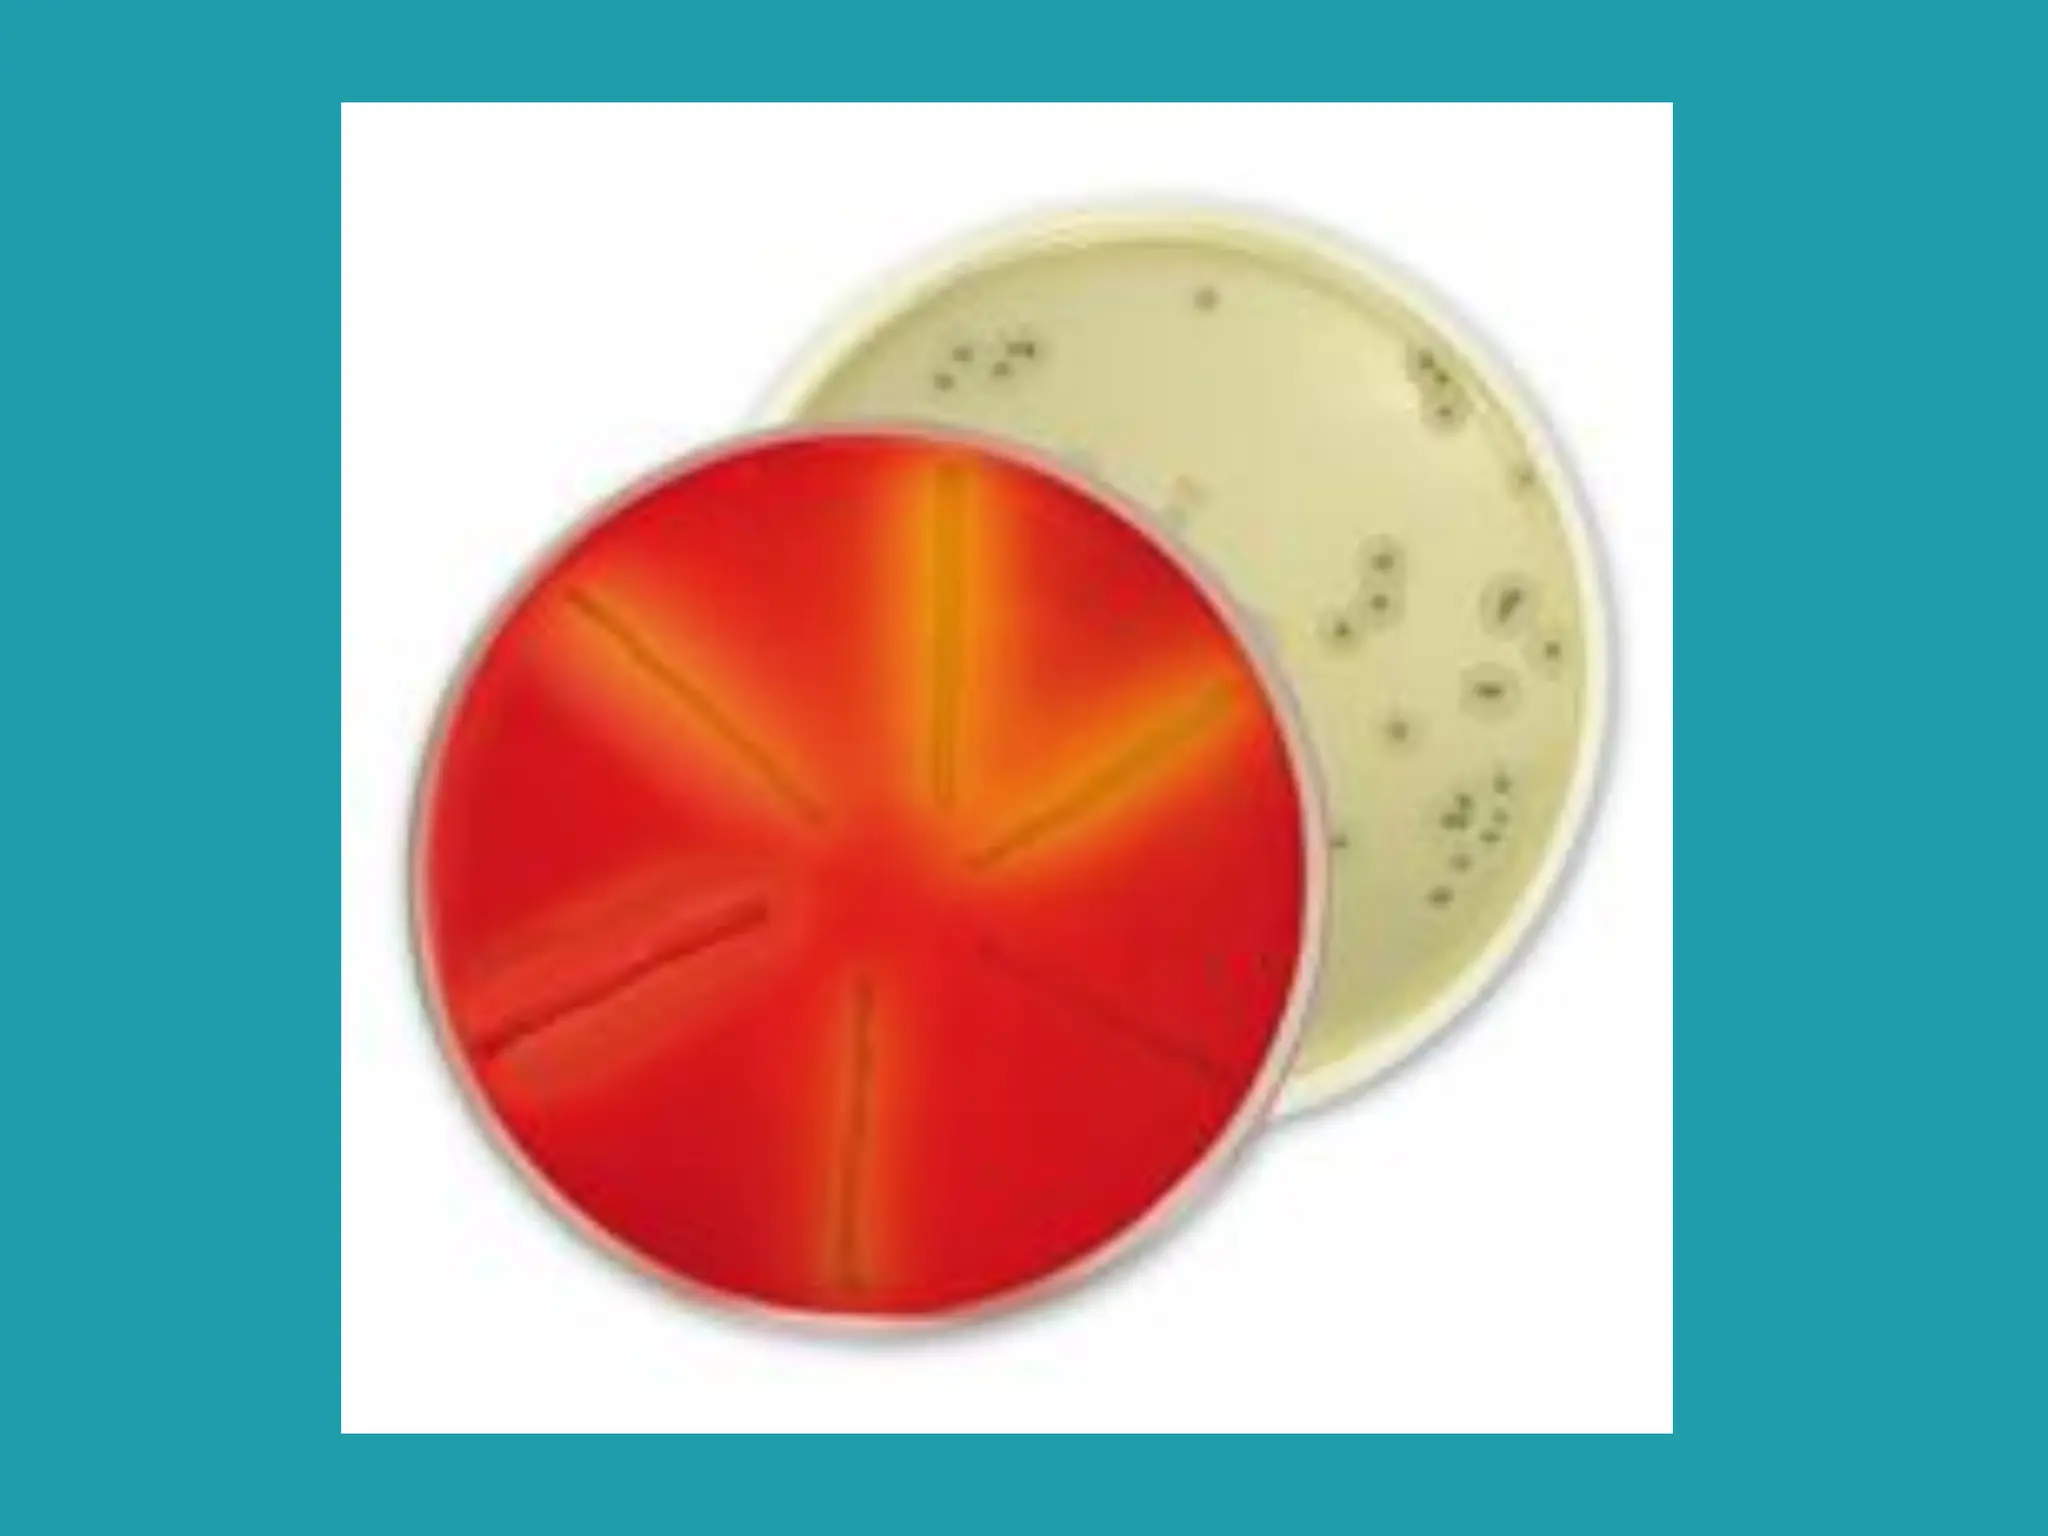
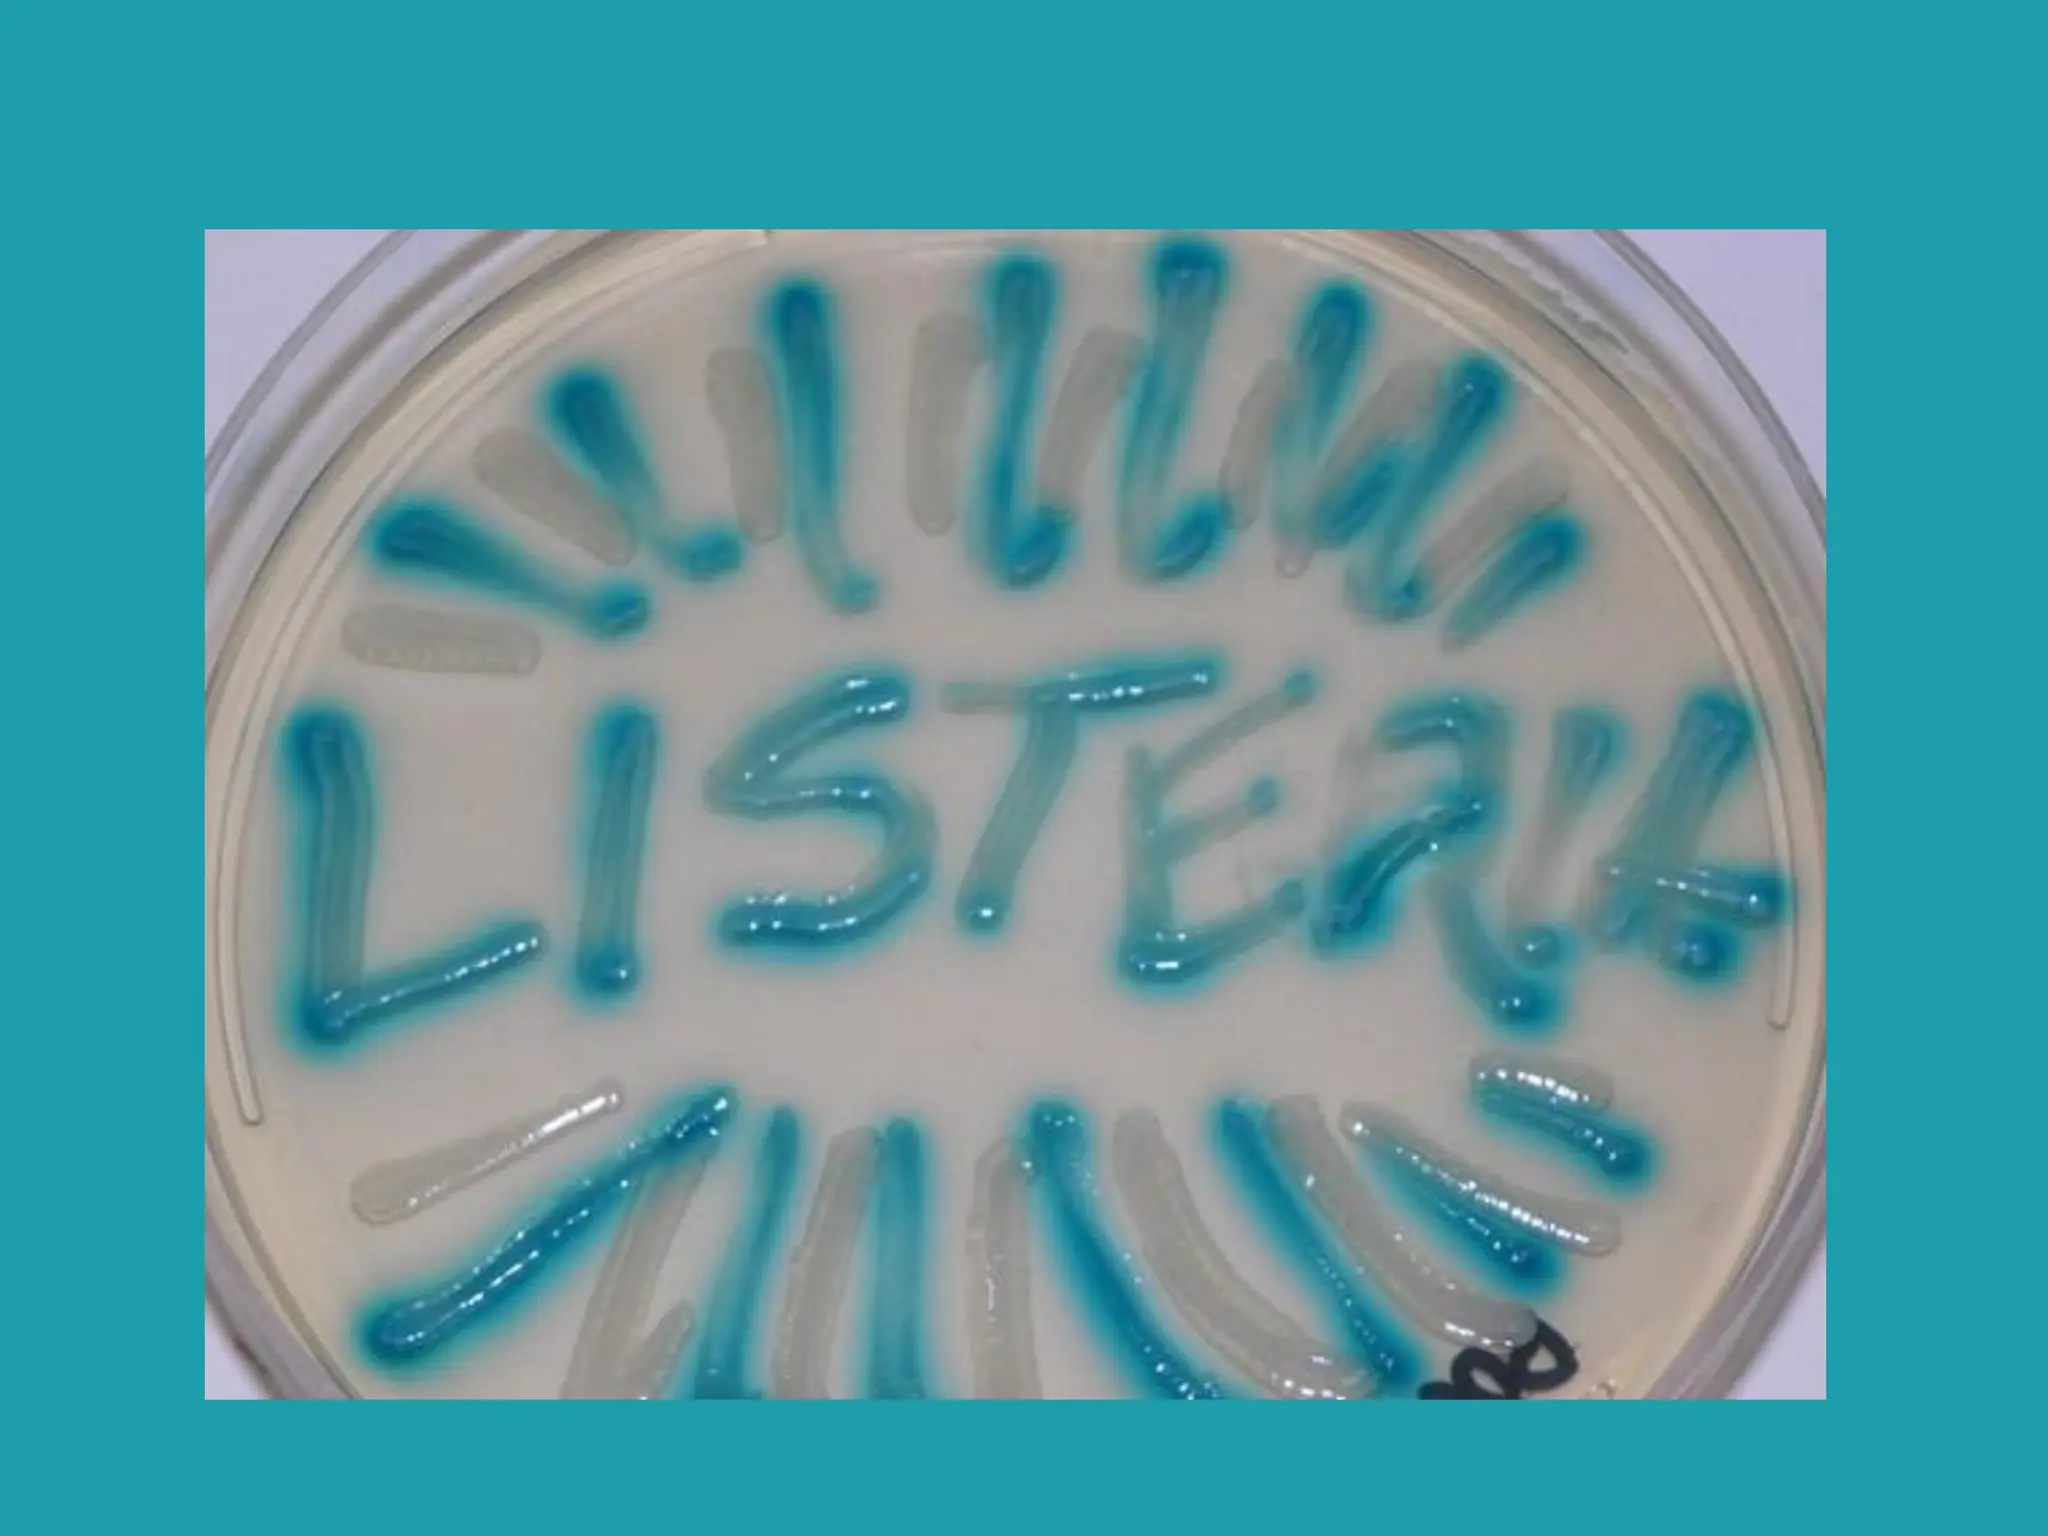
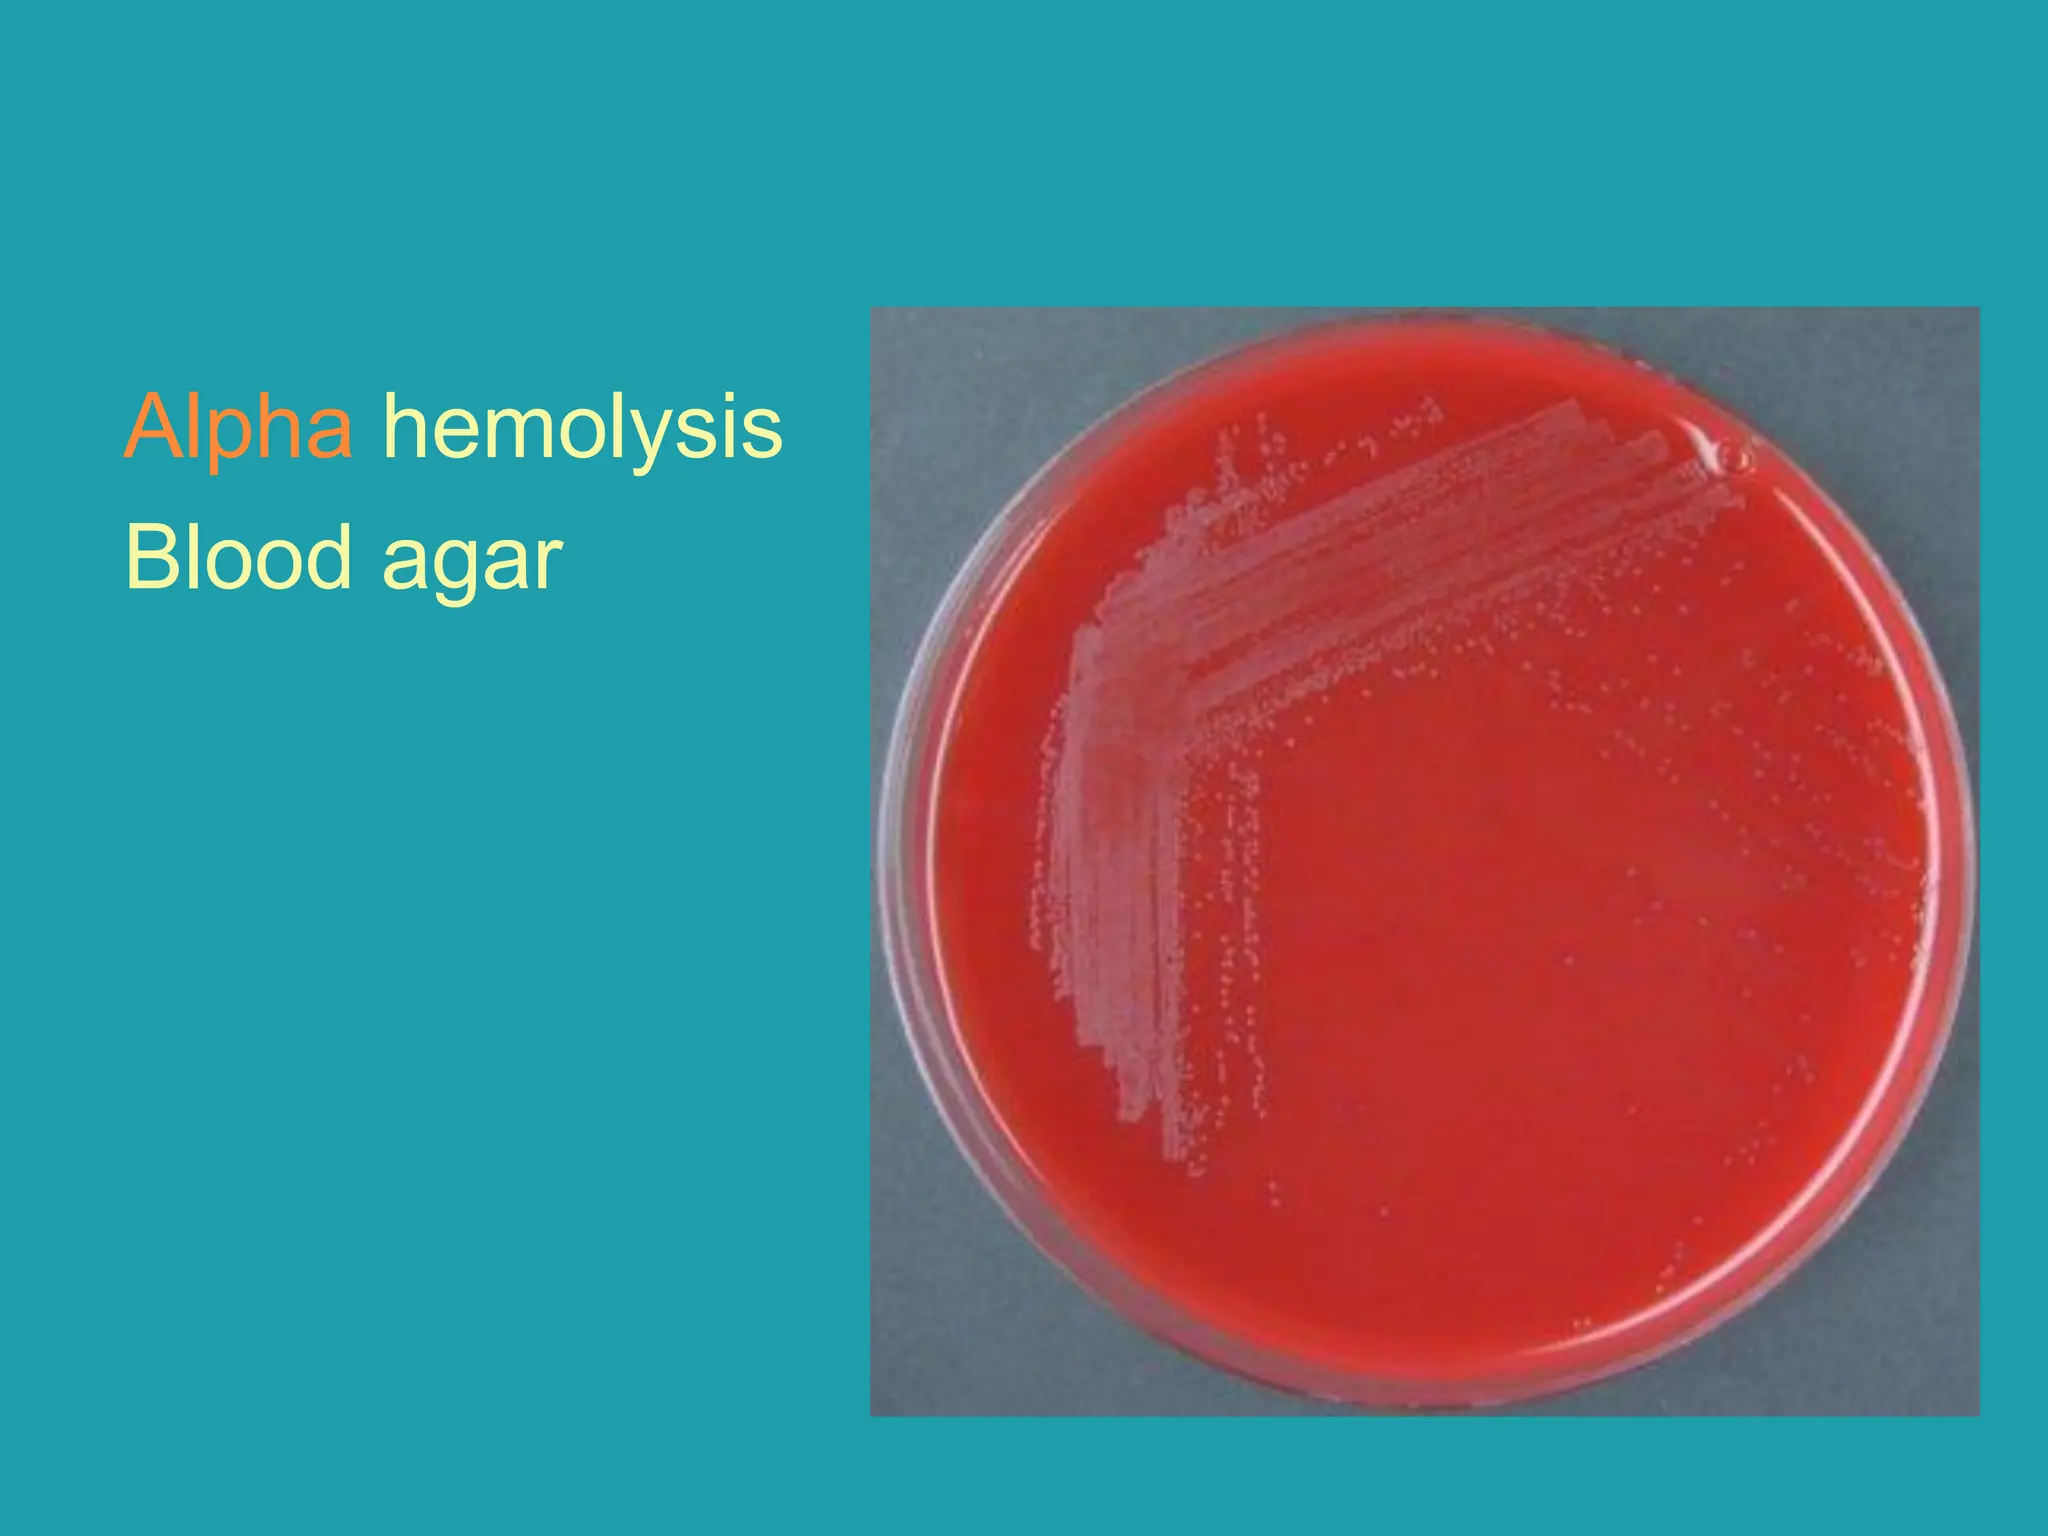
Alpha hemolysis
Blood agar

This document provides information on various actinomycetes bacteria including Nocardia, Actinomadura, Streptomyces, Actinomyces, as well as Listeria monocytogenes, Erysipelothrix rhusiopathiae, and Gardnerella vaginalis. It describes their morphology, culture characteristics, and roles in diseases like mycetoma, actinomycosis, listeriosis, erysipeloid, and bacterial vaginosis. Specimens for diagnosis include pus, sputum, infected tissue, blood, and cerebrospinal fluid which can be examined microscopically and cultured to identify the causative bacteria.